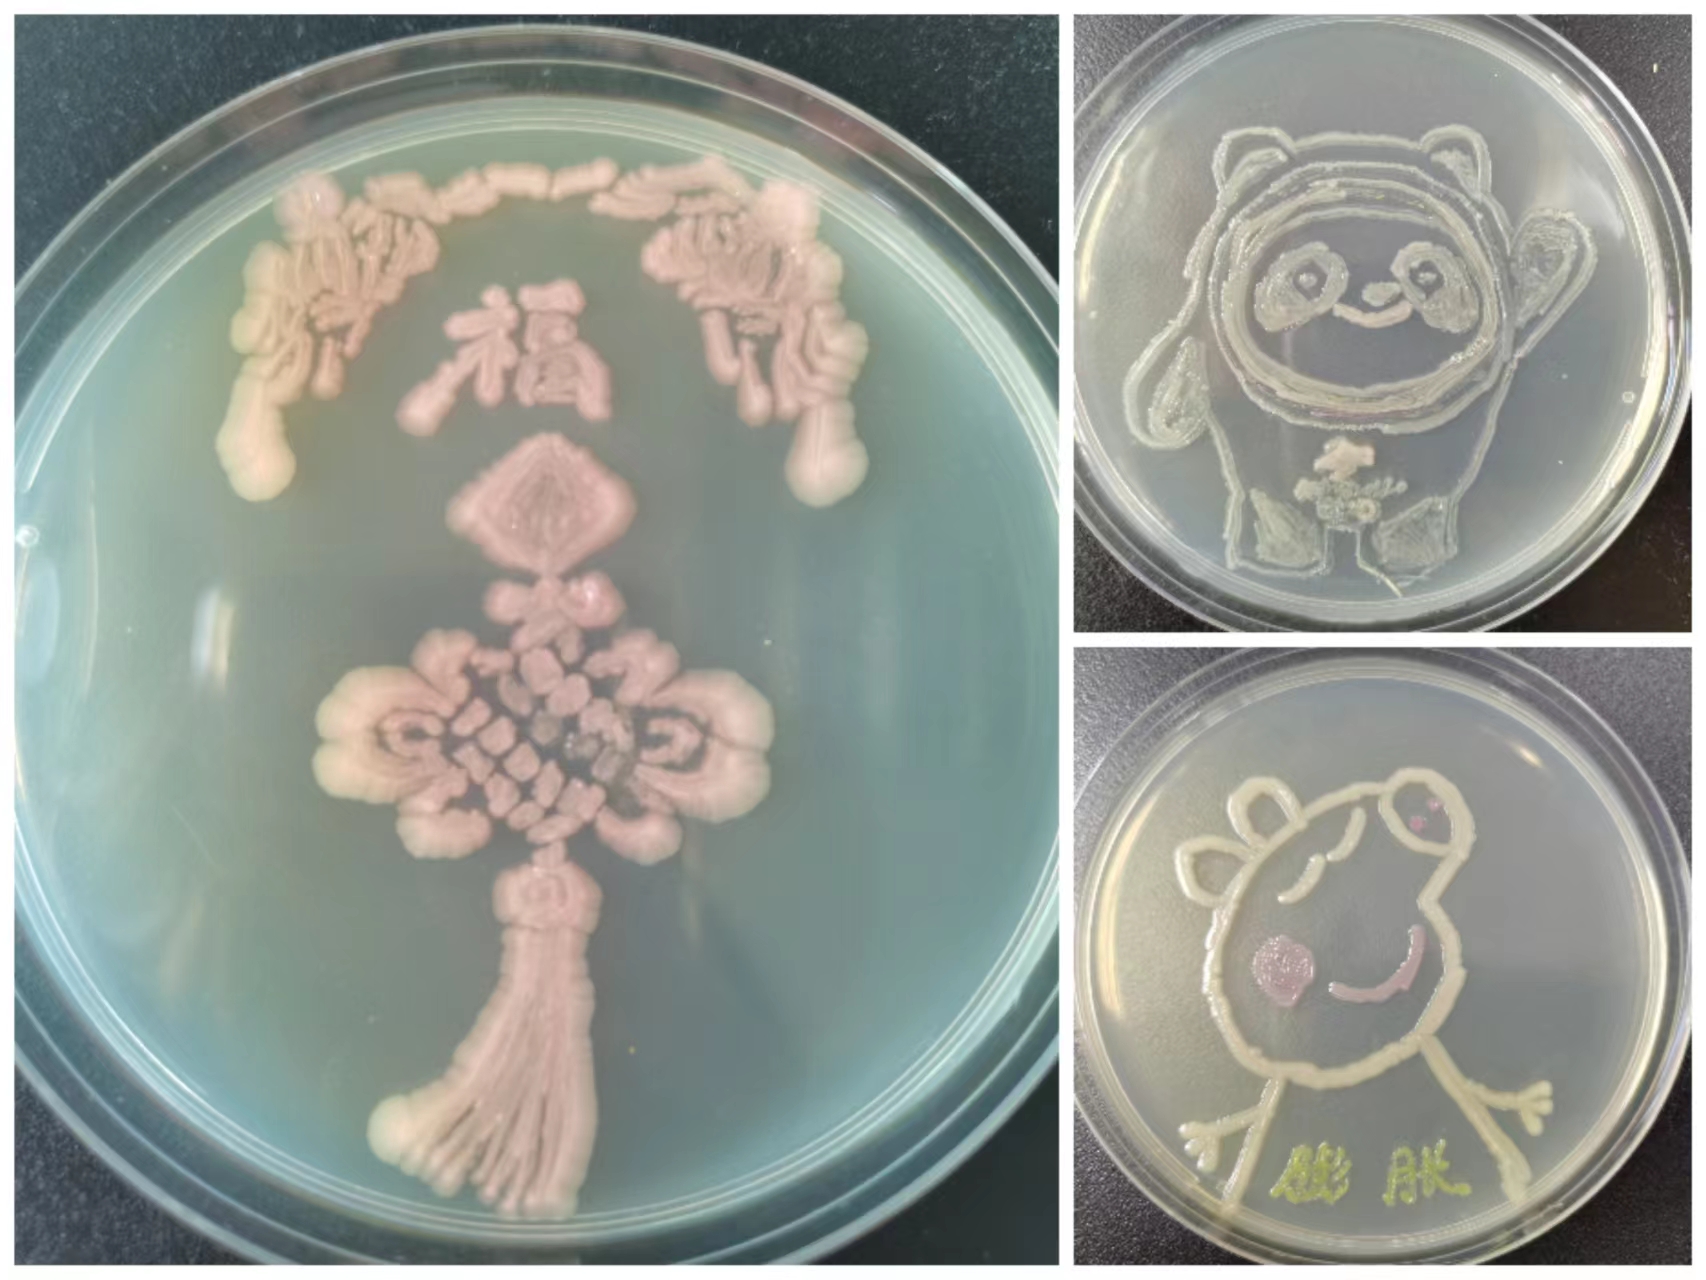

中国科学院微生物研究所“我爱微世界”摄影大赛作品展
时间:2022/07/27
为迎接建党101周年,引导全所广大职工、学生心系“国家事”、肩扛“国家责”,弘扬和传承劳模精神、劳动精神、工匠精神,激发科研兴趣,凸显微生物学科特色,展现微观世界的美丽画卷,在所内营造创新氛围,微生物研究所于6月8日—7月14日举办了“我爱微世界”摄影大赛,活动总共收到了来自所内职工学生们200余件作品。
所有展示作品分为显微摄影、微距摄影摄像、标本制作、培养皿作画、微生物手绘五大类,作品从科学性、艺术性、技术性三个方面体现了微生物领域的奇特之美,分享了研究所科研人员的独特创意和奇思妙想,培养了职工和学生在科研活动中的创新意识,激发了大家的科研兴趣,提高了动手能力,加深了对显微摄影技术的理解,搭建了不同领域方向科研工作者间展示与交流的平台。最终所有作品将由评委们评选出一二三等奖并授予荣誉证书,所工会及研究生部将为所有参加活动的人员提供一份精美的纪念品。

附件: